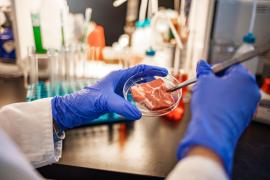
Decizie majoră privind carnea cultivată în laborator

Știri laborator
Citeste ultimele stiri pe Observator despre Laborator. Fii informat cu Observatornews.ro, site de stiri care prezinta cele mai noi informatii, reportaje si evenimente din tara si din lume.
Citeste ultimele stiri pe Observator despre Laborator. Fii informat cu Observatornews.ro, site de stiri care prezinta cele mai noi informatii, reportaje si evenimente din tara si din lume.

Alertă pentru trufandale de primăvară! Salata, spanacul, roşiile şi zarzavaturile sunt pline cu chimicale de zeci de ori peste...
pe 14.04.2026 la 19:47
Algele Mării Negre ar putea deveni aurul verde al României. Pentru prima dată, cercetătorii de la Constanţa reușesc să...
pe 08.02.2026 la 09:06
Continuă ancheta în cazul decesului fostului ministru al Justiției, Rodica Stănoiu. Primele verificări indică faptul că...
pe 17.12.2025 la 19:34
Cumperi peşte congelat dar plăteşti mai mult gheaţă. E posibil să fi păţit asta chiar azi, când a...
pe 09.12.2025 la 20:06
Chefir doar cu numele. Echipa Observator a dus la analize cel mai apreciat produs lactat de pe piaţă, chefirul. Considerat un...
pe 22.07.2025 la 19:45
Caisele, la control! Autorităţile verifică dacă fructele-vedetă din luna lui cuptor sunt româneşti, cum le prezintă...
pe 09.07.2025 la 19:54
Unul dintre cele mai mari laboratoare ilegale de droguri sintetice din România a fost descoperit într-un depozit din...
pe 21.06.2025 la 17:15
Scos la pensie de la ferma la care lucra, din cauza faptului că trăgea chiulul, un măgar şi-a găsit de lucru la Universitatea...
pe 13.06.2025 la 17:49
Celebrii "sibieni" au făcut-o de oaie. Telemeaua lor a picat testul de laborator. Am dus la analize brânză de...
pe 15.04.2025 la 20:10
Imagini incredibile vin dintr-un laborator din America. O echipă de cercetători a surprins momentul exact în care un...
pe 25.02.2025 la 12:38
Cine ajunge la Muzeul Național de Artă Timișoara, bifează nu doar frumuseţea operelor. Vizitatorii pot face acum o incursiune...
pe 16.02.2025 la 20:57
CIA a evaluat că pandemia COVID-19 este „mai probabil” să fi apărut dintr-un laborator decât din natură, a...
pe 26.01.2025 la 09:15
Doi români, doi columbieni şi un israelian, care au creat, într-o cabană dintr-o zonă izolată a judeţului Bihor,...
pe 09.01.2025 la 16:48
Specialiștii în securitate cibernetică se formează la Timișoara, în cel mai modern laborator din...
pe 07.12.2024 la 10:30
Inundaţiile au trecut, dar nu şi pericolul. În Galaţi, apa de băut e toxică. Am mers în câteva dintre...
pe 28.10.2024 la 19:30
România se pregătește să devină un producător de carne hibrid. Au fost deja obținute toate autorizațiile, astfel că...
pe 13.10.2024 la 12:13
Ne topim după îngheţată şi mâncăm anual cu kilogramele. Ce nu ştim este că, pe lângă aromele preferate -...
pe 30.08.2024 la 20:33
Carnea produsă în laborator va ajunge în scurt timp pe rafturile magazinelor! Marea Britanie devine prima ţară din...
pe 18.07.2024 la 08:47
Condimentele dau gust bun şi savoare. Dar pot acoperi şi o carne veche, care n-ar avea ce să caute pe raft. În plin sezon...
pe 28.06.2024 la 19:46
Nimic nu se compară cu gustul cartofilor noi sută la sută româneşti, crescuţi în solurile autohtone. Asta ne...
pe 31.05.2024 la 19:50
Zgârciuri în loc de carne, apă din belşug şi E.coli. Sunt ingredientele nevăzute din câteva caserole cu mici,...
pe 04.03.2024 la 20:30
O câmpie cu alge marine, întinsă, pe sute de mii de metri pătraţi, a început să fie plantată în...
pe 17.01.2024 la 20:30
Plătim bani grei pentru mâncare sănătoasă, dar ni se vând produse care ne pot îmbolnăvi. Peştele din cea...
pe 02.10.2023 la 21:11
22.000 de probe de substanţe interzise au fost analizate anul trecut în laboratoarele specializate ale Poliţiei. Toate...
pe 01.10.2023 la 20:14
Ai crede că mâncarea e mai sigură şi mai controlată în magazinele mari faţă de pieţe. În teorie, aşa...
pe 17.07.2023 la 20:01
Imagini înduioșătoare, dar dureroase. Un videoclip a surprins momentul în care un cimpanzeu a văzut cerul pentru...
pe 28.06.2023 la 12:17
Americanii se pregătesc să mănânce carne de pui făcută în laborator. Primele două companii care produc aşa ceva...
pe 22.06.2023 la 22:41
Două companii americane, Upside Foods şi Good Meat, vor putea să-şi vândă carnea cultivată din celule în...
pe 22.06.2023 la 09:05
Cluj Napoca, 31 mai, 2023. Rețeaua de sănătate REGINA MARIA, lider în calitatea serviciilor medicale din România,...
pe 02.06.2023 la 15:43
Japonia spune că ar putea crea copii în laborator în maximum cinci ani! Oamenii de ştiinţă japonezi sunt pe cale...
pe 26.05.2023 la 08:15
Un nou raport al Senatului american întăreşte ipoteza potrivit căreia virusul care a provocat pandemia de Covid-19 a...
pe 18.05.2023 la 13:45
Riscurile biologice sunt "foarte ridicate" în Sudan, după ocuparea unui laborator naţional de sănătate de...
pe 25.04.2023 la 15:20
Continuă ancheta în dosarul care vizează primul laborator de substaţe anabolizante din România , descoperit de...
pe 30.03.2023 la 14:10
Primul laborator de substanţe anabolizante din România a fost descoperit după o acţiune desfăşurată de DIICOT şi...
pe 29.03.2023 la 12:35
România ia măsuri de precauţie după cutremurul devastator care a omorât peste 47.000 de oameni în...
pe 20.02.2023 la 21:34
Cel mai bun restaurant din lume se închide la finalul anului viitor! Cheful care a pus Noma pe harta gastronomică a...
pe 10.01.2023 la 21:12
Oamenii de ştiinţă din Statele Unite se pregătesc să facă un anunţ istoric. Marţi, ar trebui să aflăm dacă aceştia au...
pe 13.12.2022 la 08:32
Noul proprietar al Twitter, Elon Musk, i-a transmis preşedintelui francez Emmanuel Macron că, "absolut", copiii...
pe 11.11.2022 la 19:05
Reuşită istorică a oamenilor de ştiinţă de la Universitatea Cambridge. Au reuşit să creeze în laborator un embion de...
pe 26.08.2022 la 22:00
O asociaţie pentru protecţia animalelor caută stăpâni pentru 4 mii de exemplare de Beagle, salvate de la un crescător...
pe 12.08.2022 la 09:29
Aproape 4.000 de căţei rasa beagle caută adăpost după ce au fost implicaţi în una dintre cele mai mari misiuni de...
pe 10.08.2022 la 19:09
Propaganda rusă pune pierderile suferite de armata rusă la începutul războiului pe seama unor experimente pentru a crea...
pe 20.07.2022 la 15:13
Membrii cartelurilor din Columbia au transformat Europa în a doua cea mai mare piaţă de desfacere din lume. Odată prinşi...
pe 14.07.2022 la 20:26
Cocaină extrasă din cafea într-un laborator în creierii munţilor . Nu este o secvenţă din Narcos. Chiar s-a...
pe 12.07.2022 la 19:26
O grupare de traficanţi de droguri de mare risc a fost descoperită în Bihor. Aceştia ar fi adus în ţară kilograme...
pe 12.07.2022 la 14:11
Un laborator unde se fabrica drogul sintetic Ecstasy a fost descoperit în vecinătatea unei baze militare belgiene despre...
pe 29.06.2022 la 10:54
Mai mulţi profesori dedicaţi din comuna Gheorghe Lazăr din Ialomiţa au avut un vis. Să le deschidă elevilor apetitul pentru...
pe 08.12.2021 la 08:20
Universitatea "Dunărea de Jos" din Galați nu se încurcă atunci când vine vorba de materialul didactic. Cercetătorii de aici...
pe 11.10.2021 la 08:15
Cel mai mare laborator clandestin de droguri sintetice identificat vreodată în Olanda a fost descoperit în noaptea de joi spre...
pe 31.07.2021 la 12:05
În viitor vom avea carne crescută în laborator. Nu va fi vegană, ci de origine animală, dar nu va necesita sacrificarea vreunui...
pe 15.07.2021 la 09:15